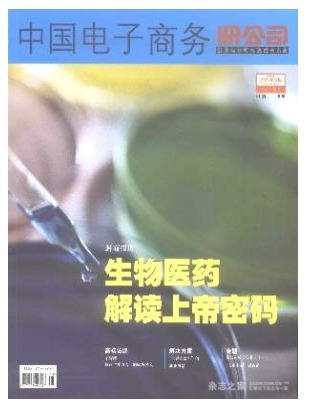
中国电子商务

投稿须知
(1)请直接在本站在线投稿,编辑会及时审理(请您投稿时准确填写您的联系方式,以便稿件录用和杂志出刊后及时与您联系)。
(2)不违反宪法和法律,不损害公共利益。
(3)是作者独立取得的原创性、学术研究成果,不侵犯任何著作权和版权,不损害第三方的其他权利。
期刊图片
←
→

中国电子商务

中国电子商务

中国电子商务

中国电子商务

中国电子商务

中国电子商务
中国电子商务

中国电子商务















